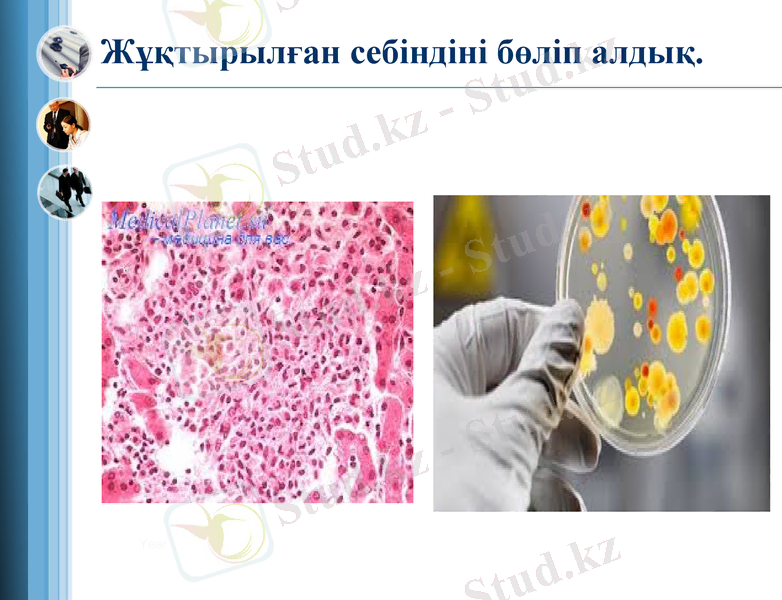
Slide 10

Бактериялогиялық зерттеу нәтижелерін талдау және сальмонеллезді анықтау әдістері



Бактериялогиялық зерттеу нәтижелерін талдау

[ Image information in product ]
Image :www. photosclub. co. kr / CD_Global Business&communication(ImageStates)
Note to customers : This image has been licensed to be used within this PowerPoint template only.
You may not extract the image for any other use.
Біз бактериологиялық зерттеудің басында патологиялық материалдар: майлы жіліктер, жүрек, бауыр, өкпе, көкбауыр, бүйректер, лимфа түйіндері, қан, ірің, сүт және тағы басқалардың ұлпаларынан жағынды препараттар дайындадық

Себінді жасау
Гисс ортасы
ЕПС
ЕПА

Бөліп алған өсінділерден дайындалған препараттарды микроскоппен қарадық
Add your title in here
.
.
Notes: Content Layouts

Биохимиялық қасиеттерін зерттеу
Зардапты микробтардың түрін анықтау кезінде олардағы сахаролитикалық және протеолитикалық ферменттердің маңызы зор. Сахаролитикалық және протеолитикалық ферменттерді анықтау үшін Гисс ортасына себінді жасайды. Сахаролитикалық ферменттердің арқасында бактериялар көмірсуларды және көп атомды спирттерді қышқыл мен газға дейін ыдыратады. Газдың түзілгенін аңғару үшін сұйық Гисс ортасына қалытқылар орналастырады. Қышқыл түзілгеніне ортадағы индикатор арқылы көз жеткізеді (Андрадэ индикаторы) . Егер микробта фермент болмаса онда олар ортаны біртекті лайлап, кәдімгі қоректік орта сияқты өсе береді. Ортаның түсі өзгермейді. Егер қантты ыдырату кезінде газ түзетін болса онда қалытқыны көтеріп жібереді.

Антигендік қасиетін анықтау
01
02
02
“

Зардаптылық қасиеттерін зерттеу. Биосынама қою.
Ақ тышқанды қолмен немесе пинцетпен құйрығынан
ұстап бекітеді. Бас бармақ немесе сұқ саусақпен
құлағынан немесе желке терісінен ұстайды. Сонда
жануардың тыпыршуына жол бермейтін тері
бүрмесі пайда болады.
Ақ тышқанды зақымдау.
Құрсақ қуысы арқылы - жануарды шалқасынан
ұстап басын бекіткеннен кейін, шприцтің инесін
қарынның төменгі 3/1 бөлігіне ақ сызықтан сәл
ауытқыған жерге салады. Мөлшері 0, 1-0, 2 мл
аспауы керек .


Лабораториялық жануарлардың өлексесін бактериологиялық тексеруден өткіздік.
Жұқтырылған себіндіні бөліп алдық.
Year

Ауру қоздырғышының САЛЬМОНЕЛЛЕЗ екені анықталды.

Сальмонеллез - жұқпалы ішек ауруы. Аурудың қоздырғышы - сальмонелла туысына жататын таяқшалы бактериялар. Бұл бактерияларды алғаш рет 1885 ж. Америка ғалымдары Дж. Смит пен Д. Е. Сальмон обамен ауырған шошқалардан тапқан. Қазіргі кезде 2500-ден астам сальмонелла бактериясыбар. Сальмонеллалар сыртқы ортада қолайлы жағдай туса, көбейе береді. Олар суда 5, ет-шұжық, сары майда 4 айға, сүтте 20 күнге, ірімшікте 1 жылға дейін тіршілігін жоймайды. Малға беретін жемдерде 10 ай, топырақта 18 айға дейін сақталады. Сальмонеллар - негізінен көптеген жабайы және үйжануарларының ішек жолының қалыпты микрофлорасы.

АдамдарғаСальмонеллез әр түрлі үй жануарлары мен құстардан жұғады. Ауру, әсіресе, нәрестелер мен қарт адамдарда ауыр өтеді. Ауруды лабораторияда арнайы бактериологиялық (қан, нәжіс, құсық қалдығы, т. б. алынады) және серологиялық әдіспен (Видаль реакциясы, т. б. ) анықтайды.

Емі: асқазанды жедел жуып-шаяды, дененің улануын әлсірететін, жоғалтқан тұз-су балансын қалпына келтіретін әр түрлі сұйықтықтарды тамырға құю, витаминдер, бактериофагтар, антибиотиктер (левомицетин, циклофлоксацин, т. б. ) қабылдау. Сальмонеллез бен күресу және оның алдын алу үшін санитариялық, гигиеналық, ветеринариялық және індетке қарсы шаралар кешені жүргізіледі.

Назарларыңызға рақмет!!!
- Іс жүргізу
- Автоматтандыру, Техника
- Алғашқы әскери дайындық
- Астрономия
- Ауыл шаруашылығы
- Банк ісі
- Бизнесті бағалау
- Биология
- Бухгалтерлік іс
- Валеология
- Ветеринария
- География
- Геология, Геофизика, Геодезия
- Дін
- Ет, сүт, шарап өнімдері
- Жалпы тарих
- Жер кадастрі, Жылжымайтын мүлік
- Журналистика
- Информатика
- Кеден ісі
- Маркетинг
- Математика, Геометрия
- Медицина
- Мемлекеттік басқару
- Менеджмент
- Мұнай, Газ
- Мұрағат ісі
- Мәдениеттану
- ОБЖ (Основы безопасности жизнедеятельности)
- Педагогика
- Полиграфия
- Психология
- Салық
- Саясаттану
- Сақтандыру
- Сертификаттау, стандарттау
- Социология, Демография
- Спорт
- Статистика
- Тілтану, Филология
- Тарихи тұлғалар
- Тау-кен ісі
- Транспорт
- Туризм
- Физика
- Философия
- Халықаралық қатынастар
- Химия
- Экология, Қоршаған ортаны қорғау
- Экономика
- Экономикалық география
- Электротехника
- Қазақстан тарихы
- Қаржы
- Құрылыс
- Құқық, Криминалистика
- Әдебиет
- Өнер, музыка
- Өнеркәсіп, Өндіріс
Қазақ тілінде жазылған рефераттар, курстық жұмыстар, дипломдық жұмыстар бойынша біздің қор #1 болып табылады.



Ақпарат
Қосымша
Email: info@stud.kz